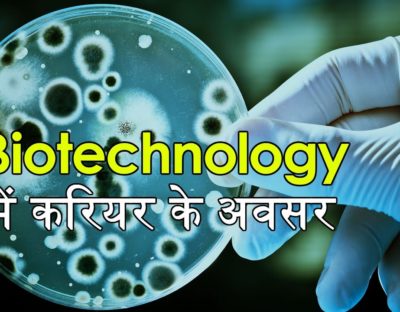
post-image

Latest Videos
वैज्ञानिकों की एक अंतरराष्ट्रीय टीम ने, फ़्लैश-फ़्रोज़न सैंपल और इलेक्ट्रॉन माइक्रोस्कोपी का इस्तेमाल करके, पहली बार हमारे रेटिना...
NASA ने अंतरिक्ष में घूम रही स्विफ़्ट ऑब्ज़र्वेटरी को बचाने के लिए एक अनोखे मिशन को लांच किया है।...
मुंबई की फार्मा कंपनी वॉकहार्ट ने इतिहास रच दिया है। कंपनी द्वारा पूरी तरह से भारत में विकसित...
27 जून 2026 को राजस्थान के उदयपुर एयरपोर्ट पर एक IndiGo Airbus A320 की ‘लैंडिंग’ ऐतिहासिक बन गई ।...
भारत ने स्वच्छ ऊर्जा के क्षेत्र में एक बड़ी उपलब्धि हासिल की है। तमिलनाडु के कल्पक्कम में भारत...
एक नए अध्ययन में चूहों पर किए गए प्रयोगों से पता चला है कि गर्भावस्था और जीवन के...
29 और 30 जून 2026 की पूर्णिमा को आप स्ट्रॉबेरी मून को देख सकते हैं, जो नॉर्दर्न हेमिस्फीयर में,...
News
Research
Posted on
शुभांशु शुक्ला का संस्मरण “The Second Orbit: Belief of a Man… Dreams of 1.4 Billion Hearts”
भारतीय एस्ट्रोनॉट शुभांशु शुक्ला की ऐतिहासिक space flight की पहली वर्षगांठ पर, उनके संस्मरण “The Second Orbit: Belief...